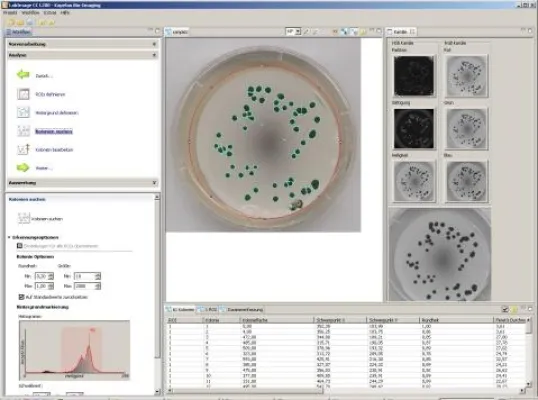
Bild: Neue Software zur automatischen Zählung von Kolonien und Spots in der Biologie, Medizin und Mikrobiologie.

(openPR) Kapelan Bio-Imaging veröffentlicht mit LabImage 1D die weltweit aktuellste Software für 1D Gel Analyse für die Macintosh Plattform.
Der Einsatz von Macintosh-Systemen ist in der Forschung weltweit mehr und mehr auf dem Vormarsch. Allein in den USA sind bis zu 50 % der genutzten Systeme Mac's. Auch in Europa steigen die Nutzerzahlen permanent.
Grund genug für Kapelan Bio-Imaging ihre Software LabImage 1D für die Auswertung von 1D Elektrophorese Gelen auch für die Macintosh-Plattform zu veröffentlichen. Dabei setzt Kapelan Bio-Imaging auf das einfache und workflow basierte Nutzerinterface, das bereits für Windowssysteme seit 4 Jahren erfolgreich am Markt etabliert ist.
"Liefern andere Anbieter ihre Software für den Mac nur über aufwendige Softwareemulationen", so Geschäftsführer Olaf Brenn, "so setzt Kapelan Bio-Imaging auf eine Lösung, die nativ auf dem Betriebssystem arbeitet". LabImage 1D erscheint deswegen im Mac "Look and Feel" und integriert sich nahtlos als typische Mac Software.
LabImage 1D ist damit die weltweit aktuellste Software in dem Segment für die Macintosh-Plattform. Ähnlich wie bei der Windows Version profitieren Mac Nutzer von der einfachen Bedienung, dem hohen Grad der Automatisierung und einem flexiblen Export und Reporting von Analysedaten. Dabei macht Kapelan keinen Unterschied im Preis. Mac und Windows Lizenzen sind darüber hinaus auch als Arbeitsplatz- oder Netzwerklizenzen verfügbar.
Kapelan Bio-Imaging schöpft mit dem Release von LabImage 1D für Macintosh-Systeme die Leistungsfähigkeit der eigenen Softwareplattform weiter aus. Diese Plattform basiert auf der Programmiersprache Java, die auf einer Vielzahl von Betriebsystemen und damit auch auf Macintosh-Systemen einsetzbar ist. Damit geht Kapelan Bio-Imaging einen weiteren Schritt in Richtung der plattformunabhängigen Lösungen in der Bioinformatik.
Presseinformation
Kapelan veröffentlicht LabImage 1D für MAC OS X


Diese Pressemeldung wurde auf openPR veröffentlicht.
Verantwortlich für diese Pressemeldung:Olaf Brenn
Kapelan Bio-Imaging
Prager Str. 60
04317 Leipzig
Germany
Tel: +49 341 35599770
Email:
Web: www.kapelan-bioimaging.com
Kapelan Bio-Imaging
Prager Str. 60
04317 Leipzig
Germany
Tel: +49 341 35599770
Email:
Web: www.kapelan-bioimaging.com
Über das Unternehmen
Kapelan Bio-Imaging – Bioinformatik aus Mitteldeutschland
Kapelan Bio-Imaging ist ein Bioinformatik-Unternehmen mit Sitz in Leipzig. Das 2001 gegründete Unternehmen entwickelt Software für digitale Bildauswertung im Life Science Bereich.
Das Team aus Bioinformatikern und Life Science Spezialisten um Geschäftsführer Olaf Brenn hat sich zum Ziel gesetzt, leistungsfähige und einfach bedienbare Softwarelösungen für den wachsenden Markt der Bioinformatik zu entwickeln. Kapelan Bio-Imaging bietet dazu alle Leistungen, um automatisierte Auswerteprozesse in Medizin, Biologie, Forschung und Routine zu etablieren.
Auf der Basis einer eigenen Software-Plattform kann Kapelan Bio-Imaging von der Entwicklung von Prototypen bis hin zu GLP-konformen Softwaresystemen eine breite Palette an Lösungen für verschiedene Betriebsysteme anbieten. Kapelan Bio-Imaging ist weltweit führend im Bereich der Auswertung der 1D Elektrophorese.
Kapelan Bio-Imaging ist ein Bioinformatik-Unternehmen mit Sitz in Leipzig. Das 2001 gegründete Unternehmen entwickelt Software für digitale Bildauswertung im Life Science Bereich.
Das Team aus Bioinformatikern und Life Science Spezialisten um Geschäftsführer Olaf Brenn hat sich zum Ziel gesetzt, leistungsfähige und einfach bedienbare Softwarelösungen für den wachsenden Markt der Bioinformatik zu entwickeln. Kapelan Bio-Imaging bietet dazu alle Leistungen, um automatisierte Auswerteprozesse in Medizin, Biologie, Forschung und Routine zu etablieren.
Auf der Basis einer eigenen Software-Plattform kann Kapelan Bio-Imaging von der Entwicklung von Prototypen bis hin zu GLP-konformen Softwaresystemen eine breite Palette an Lösungen für verschiedene Betriebsysteme anbieten. Kapelan Bio-Imaging ist weltweit führend im Bereich der Auswertung der 1D Elektrophorese.
Pressebericht „Kapelan veröffentlicht LabImage 1D für MAC OS X“ bearbeiten oder mit dem "Super-PR-Sparpaket" stark hervorheben, zielgerichtet an Journalisten & Top50 Online-Portale verbreiten:
Disclaimer: Für den obigen Pressetext inkl. etwaiger Bilder/ Videos ist ausschließlich der im Text angegebene Kontakt verantwortlich. Der Webseitenanbieter distanziert sich ausdrücklich von den Inhalten Dritter und macht sich diese nicht zu eigen. Wenn Sie die obigen Informationen redaktionell nutzen möchten, so wenden Sie sich bitte an den obigen Pressekontakt. Bei einer Veröffentlichung bitten wir um ein Belegexemplar oder Quellenennung der URL.
Weitere Mitteilungen von Kapelan Bio-Imaging


Das digitale Auge im Labor - LabImage ermöglicht vollautomatisierte und präzise Auswertung digitaler Bilddaten
Leipzig, 21. Juli 2011 - Als einer der weltweit führenden Anbieter von Softwarelösungen für die Analyse digitaler Bilddaten (Bio-Imaging) hat das sächsische Unternehmen Kapelan Bio-Imaging mit Sitz in Leipzig eine einzigartige Softwareplattform entwickelt. Die Softwarelösung namens LabImage ermöglicht eine vollautomatisierte Auswertung komplexer Bilddaten im Labor. Das Leistungsspektrum umfasst die Probenanalyse bis hin zur Prozessdokumentation und Ergebnisauswertung. In der Praxis ist die neuartige Softwareumgebung seit fünf Jahren marktreif…


Bio-Imaging Plattform reduziert Aufwand zur Entwicklung von Software in Medizin und Forschung.
Der deutsche Bioinformatik Spezialist Kapelan Bio-Imaging aus Leipzig erweitert seine Produktfamilie um eine neue Software Plattform, die den Aufwand zur Entwicklung von Software im Bereich der Medizin dramatisch verkürzen wird.
Die neue LabImage Plattform dient als gemeinsame Softwarebasis für die Entwicklung individueller Anwendungen. Sie stellt die Funktionalitäten für moderne Bildanalyse über Daten-, Nutzer- und Lizenzverwaltung bis zu Gerätesteuerung zur Verfügung. Alle gegenwärtigen und zukünftigen Anwendungen von Kapelan basieren auf…
Das könnte Sie auch interessieren:


Das digitale Auge im Labor - LabImage ermöglicht vollautomatisierte und präzise Auswertung digitaler Bilddaten
… Bilddaten (Bio-Imaging) hat das sächsische Unternehmen Kapelan Bio-Imaging mit Sitz in Leipzig eine einzigartige Softwareplattform entwickelt. Die Softwarelösung namens LabImage ermöglicht eine vollautomatisierte Auswertung komplexer Bilddaten im Labor. Das Leistungsspektrum umfasst die Probenanalyse bis hin zur Prozessdokumentation und Ergebnisauswertung. …


PQ-Erweiterung: Erste vollständige Systemvalidierung für 1D Gele/Western Blots verfügbar
… Analysesystems für jedes 1D-Gel oder Western Blot
Die PQ-Erweiterung des Softwareanbieters Kapelan Bio-Imaging aus Leipzig ist ein neues Softwaretool, das die Fähigkeiten von LabImage 1D erweitert. Es ermöglicht Benutzern, eine vollständige Validierung des Analysesystems für jedes 1D-Gel oder Western Blot durchzuführen und so die Analysequalität für …


Borellien sicher detektieren - neue Readerserie
Das Leipziger Bioinformatik-Unternehmen Kapelan Bio-Imaging startet mit seiner eigenen Geräteserie für die Routinediagnostik unter dem Namen LabImageR. Mit dem LabImageR TR können Anwender streifenbasierte Tests beispielsweise für die Detektion von Borellien direkt aus den Prozessierungswannen lesen und auswerten. Das Leipziger Bioinformatik-Unternehmen …


Neue innovative Software für EPO-Diagnostik
LabImage 1D EPO für die EPO-Routinediagnostik
Neue Auswertesoftware aus Leipzig
Mit LabImage 1D EPO stellt Kapelan Bio-Imaging eine Softwarelösung speziell für die EPO-Routinediagnostik vor. Der Ansatz basiert auf dem etablierten LabImage 1D und vereint die Vorteile einer spezifischen Anpassungsfähigkeit an einzelne Laborprozesse mit den Möglichkeiten …


Unterstützung für Forscher weltweit aus Deutschland - kostenfreie Software aus Leipzig
… Einsatz. Der sächsische Anbieter Kapelan Bio-Imaging, der bereits seit dem Jahr 2000 im Bereich der Bildverarbeitung aktiv ist, bietet nun eine kostenfreie Version der Software LabImage 1D an.
"Unsere Intention war es, der Forschung und Lehre in diesem Segment die Arbeit mit einer Analysesoftware zu ermöglichen", erläutert Olaf Brenn, Geschäftsführer …

Neue Software zur automatischen Zählung von Kolonien und Spots in der Biologie, Medizin und Mikrobiologie.
Kapelan Bio-Imaging stellt mit LabImage CC eine neue Software zur Koloniezählung und Spotanalyse vor.
„Nutzt man bisher sein eigenes Augenmass oder einem Zählstift zur Zählung teils sehr kleiner Kolonieobjekte“ so Olaf Brenn, Geschäftsführer der Kapelan Bio-Imaging, „so kann man mit LabImage CC sehr schnell und automatisiert Kolonien auszählen“. Einige …

Neue Netflix Serie Biohackers zeigt LabImage 1D Software
LabImage 1D in neuer Netflix Serie Biohackers zu sehen
------------------------------
Der Pay TV Anbieter Netflix hat mit seinen letzten Serien bereits für viel Aufsehen gesorgt. Mit der neuen Serie Biohackers startet Netflix in Zeiten von Corona mit einem sehr aktuellen Thema. Die Serie handelt von einer Medizinstudentin, der sich auf geheimer Mission …


Kapelan Bio-Imaging und HTWK gewinnen Preis bei Leipziger Ideenwettbewerb der IHK
… HTWK Leipzig.
Ziel des Projektes ist die Schaffung eines innovativen und objektiven Darstellungsstandards für nuklearmedizinische Daten.
Dieser Standard soll auf Basis der neuen LabImage Plattform von Kapelan Bio-Imaging entwickelt und umgesetzt werden.
Die Bio-Imaging Plattform LabImage ist die aktuelle Entwicklung der Kapelan, die die Umsetzung von …


Bio-Imaging Plattform reduziert Aufwand zur Entwicklung von Software in Medizin und Forschung.
… Produktfamilie um eine neue Software Plattform, die den Aufwand zur Entwicklung von Software im Bereich der Medizin dramatisch verkürzen wird.
Die neue LabImage Plattform dient als gemeinsame Softwarebasis für die Entwicklung individueller Anwendungen. Sie stellt die Funktionalitäten für moderne Bildanalyse über Daten-, Nutzer- und Lizenzverwaltung bis zu …

Qualitätsmanagement-System nach ISO 13485 in der Softwareentwicklung vollständig implementiert
… Unternehmen in dieser Branche zwangsläufig zu einer gesteigerten Anforderung an international gültigen Zertifizierungen. Die Prozesse der Labordiagnostik (https://www.kapelanbio.com/de/produkte/labimage-apps.html) müssen nicht nur qualitativ hochwertig sein, sondern vor allen Dingen auch weltweit gültigen Standards entsprechen, um gleichermaßen transparent …
Sie lesen gerade: Kapelan veröffentlicht LabImage 1D für MAC OS X